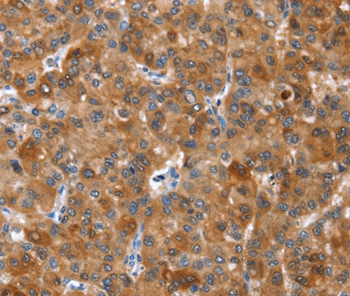
Anti-NOD2 Antibody

NOD2 Antibody
ORB253806
ApplicationsImmunoHistoChemistry
Product group Antibodies
ReactivityHuman
TargetNOD2
Overview
- SupplierBiorbyt
- Product NameNOD2 Antibody
- Delivery Days Customer16
- ApplicationsImmunoHistoChemistry
- Applications SupplierIHC
- CertificationResearch Use Only
- ClonalityMonoclonal
- ConjugateUnconjugated
- Gene ID64127
- Target nameNOD2
- Target descriptionnucleotide binding oligomerization domain containing 2
- Target synonymsACUG, BLAU, BLAUS, CARD15, CD, CLR16.3, IBD1, NLRC2, NOD2B, PSORAS1, YAOS, nucleotide-binding oligomerization domain-containing protein 2, NLR family, CARD domain containing 2, NOD-like receptor C2, caspase recruitment domain family, member 15, caspase recruitment domain protein 15, caspase recruitment domain-containing protein 15, inflammatory bowel disease protein 1, nucleotide-binding oligomerization domain 2, nucleotide-binding oligomerization domain, leucine rich repeat and CARD domain containing 2
- HostRabbit
- Protein IDQ9HC29
- Protein NameNucleotide-binding oligomerization domain-containing protein 2
- Scientific DescriptionNOD2 Antibody
- ReactivityHuman
- Storage Instruction-20°C,2°C to 8°C
- UNSPSC12352203